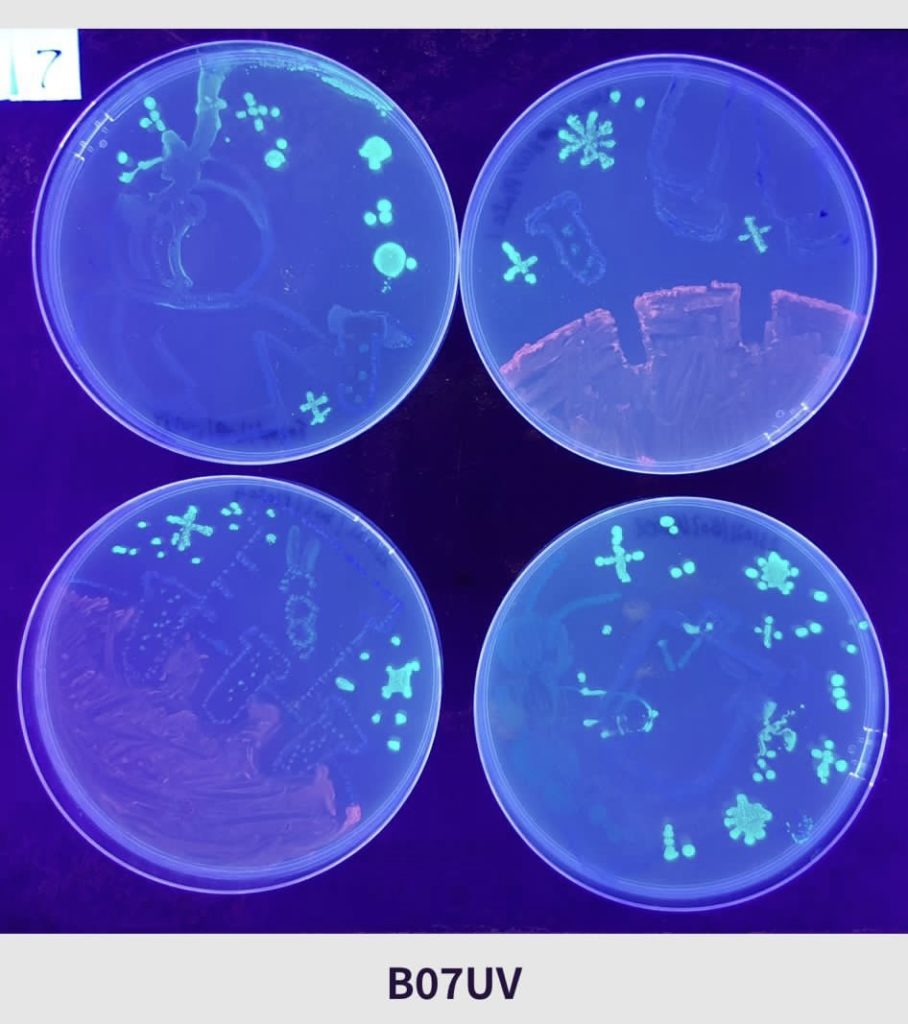

本校學生於10月27日(六)參加了嗇色園可譽中學暨小學主辦、美國微生物學會支持的「國際瓊脂藝術大賽2023(香港區賽)」,並勇奪初中組冠軍。
活動簡介:
『國際瓊脂藝術大賽2023』香港區賽,旨在提高中小學生對科學、生物科技以及STEAM (科學、技術、工程、藝術和數學) 教育的興趣。本屆香港區有接近四百名中小學生報名參賽,以『微生物在太空』為主題創作瓊脂藝術畫作。
得獎名單:
3A 吳凱迪、3A蔣家俊、3A林浠汶、3A 符巧妍
作品簡介:
“In the future, as Earth becomes increasingly uninhabitable due to human destruction, migrating to Mars is a viable option for the propagation of our next generation. To ensure a better life for us, we can cultivate space microorganisms to overcome the harsh conditions of space. Instead of cultivating plants, humans can shift to cultivating microorganisms as a new source of food.”
未來地球經已被人類摧毁得逐漸不宜居住,為了繁衍我們的下一代,移居火星是一個不錯選擇。 為了我們有更美好的生活,我們可以培育太空微生物,克服太空惡劣環境,人類不再耕種植物,改為耕種微生物,以作為人類新的糧食。